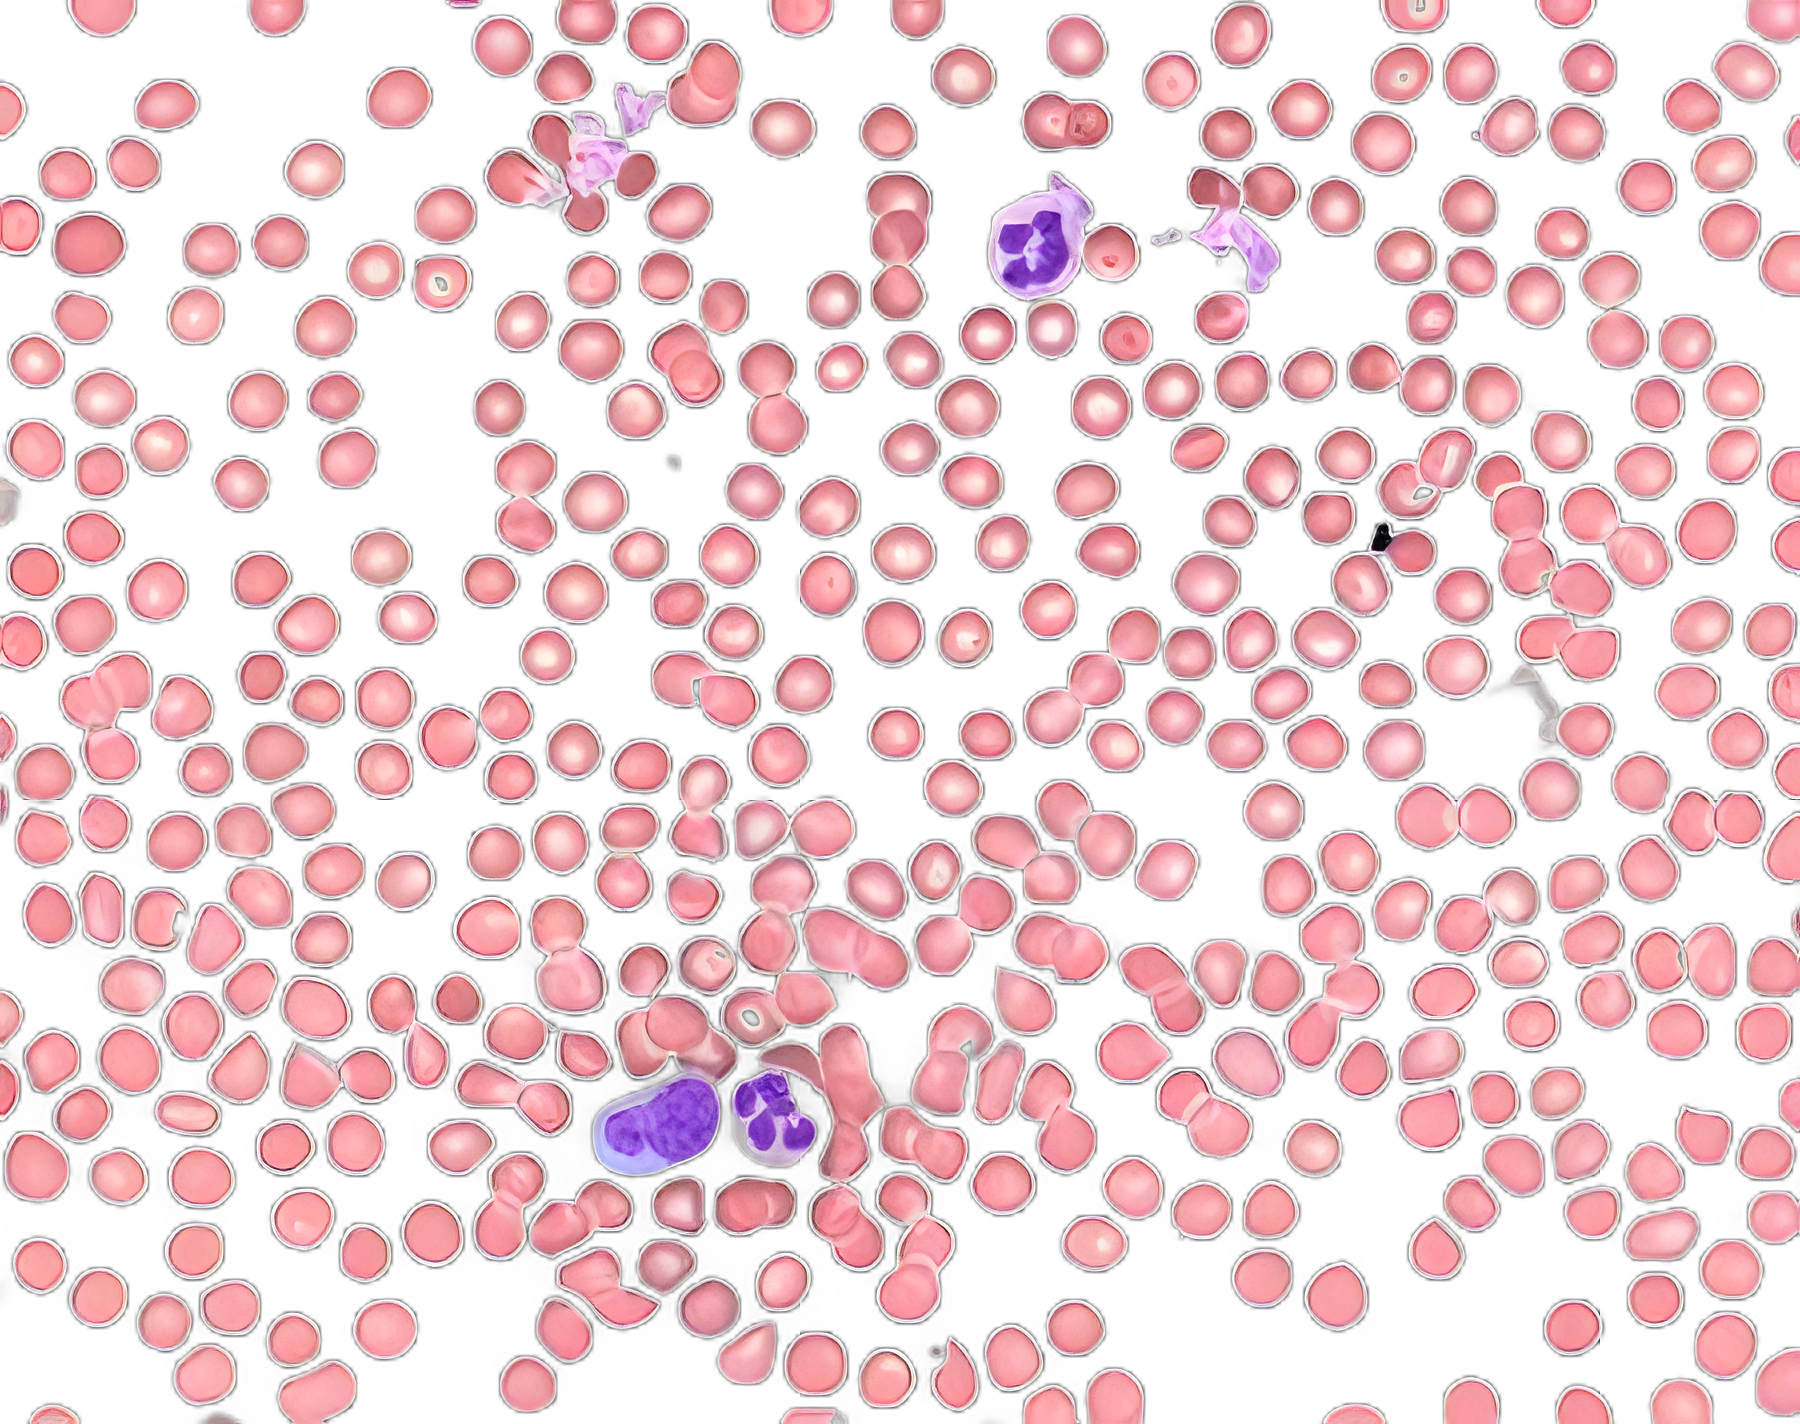

Wright's Eosin Methylene Blue Stain, 500 mL - For Blood and Bone Marrow
1013830507 | USAMP#34236538
container type
volume
Secure Checkout
Verified Supply Chain
Priority Fulfillment
More Information
Locked
Base Price
$60.12
EA
🎯 Unlock Your Custom Tiered Price
15-35% bulk discounts
100+
units
10% OFF
$XX.XX
per unit
Save $XXX
Payment Terms
Priority Shipping
Custom Contract Pricing
250+
units
20% OFF
$XX.XX
per unit
Save $XXX
Payment Terms
Priority Shipping
Custom Contract Pricing
500+
units
30% OFF
$XX.XX
per unit
Save $XXX
Payment Terms
Priority Shipping
Custom Contract Pricing
Unlock Bulk Pricing
See pricing for all volume tiers
Instant access to volume pricing. Register free to compare all tiers and calculate your exact savings.
5,000+ verified buyers
Average savings:$23,400/year
15-35% OFF
for healthcare facilities on bulk orders
24/7 Live Chat!
Instant support anytime
Product Spotlight
- Essential for staining blood, bone marrow smears, and clinical-cytological specimens, ensuring detailed cell analysis.
- Specifically designed for human-medical cell diagnosis, Wright’s Eosin Methylene Blue facilitates the investigation of human-origin sample material under microscopy.
- Meets rigorous lab standards for precision in diagnostic applications.
- WARNING: Cancer and Reproductive Harm – www.P65Warnings.ca.gov.